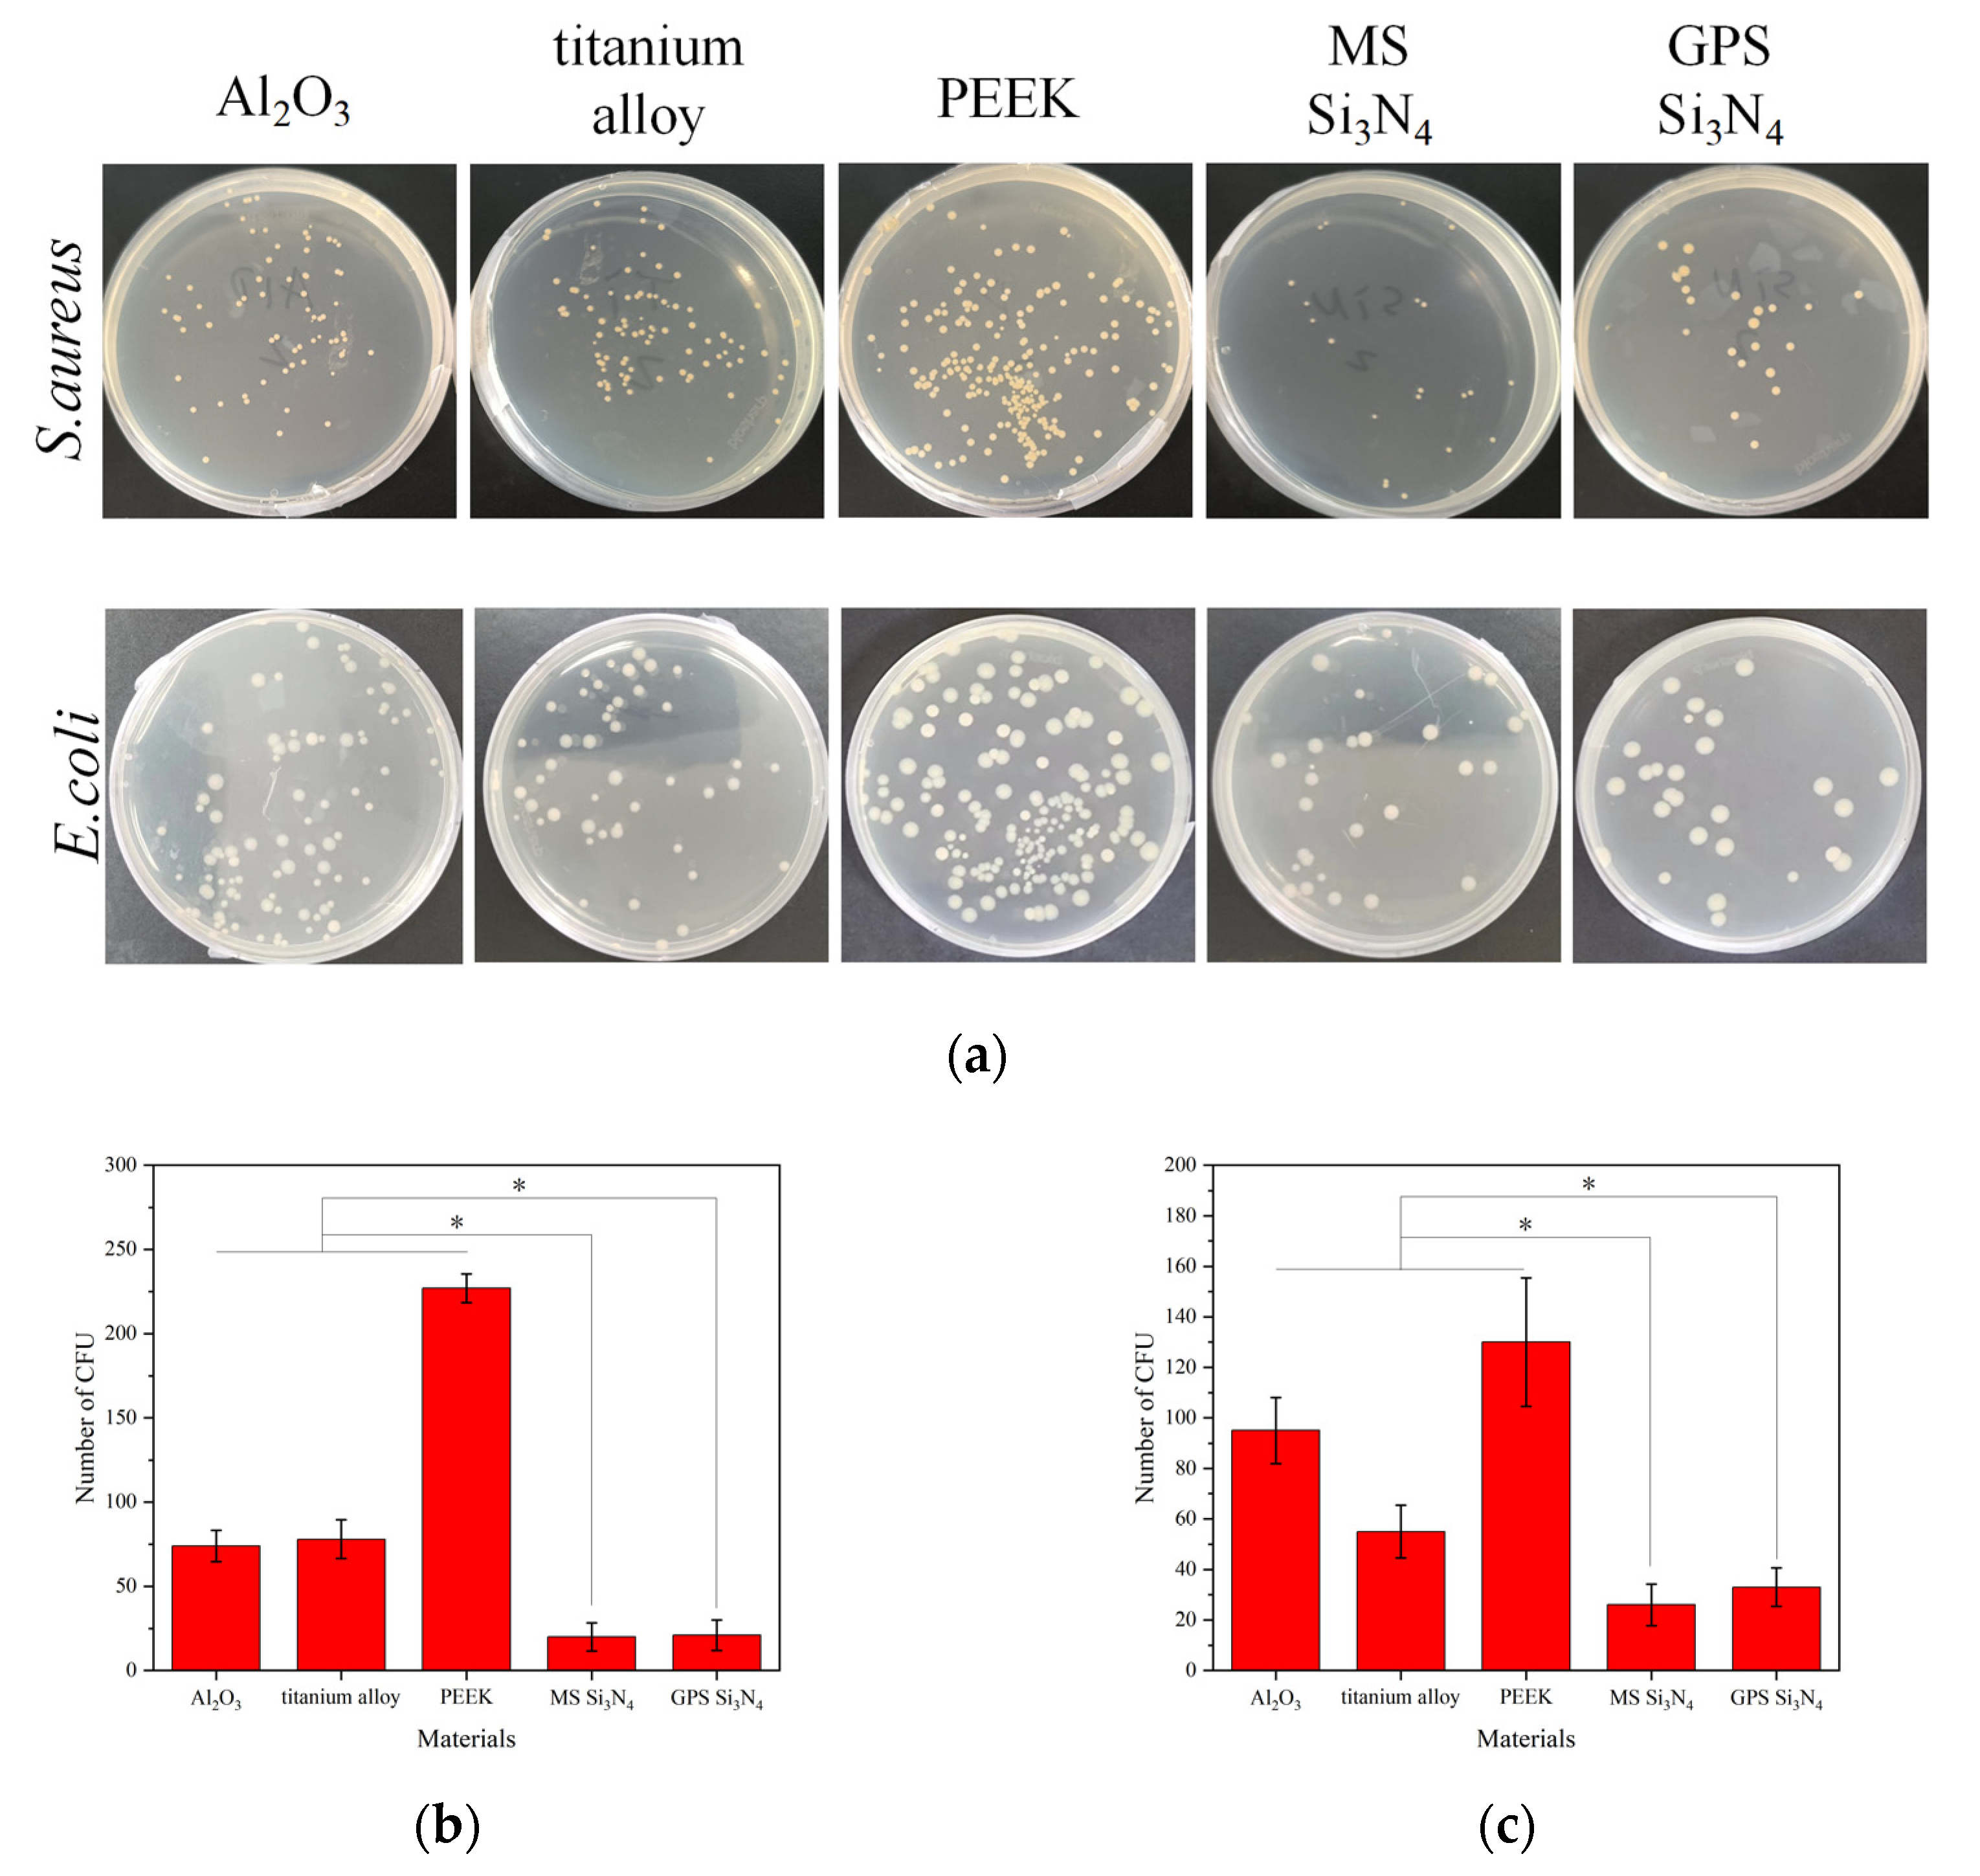
Jfb 14 00552 g005

Silicon Nitride Bioceramics Sintered by Microwave Exhibit Excellent Mechanical Properties, Cytocompatibility In Vitro, and Anti-Bacterial Properties
Abstract
:1. Introduction
2. Materials and Methods
2.1. Preparation of Materials
2.2. Physical Characterization of Materials
2.3. Cytotoxicity Test
2.4. Cell Adhesion and Morphology
2.5. Evaluation of Antibacterial Property
2.6. Statistical Analysis
3. Results
3.1. Characterization of Materials
3.2. Mechanical Properties of Materials
3.3. Cytotoxicity Determination
3.4. Cell Adhesion and Morphology
3.5. Evaluation of Antibacterial Property
4. Discussion
5. Conclusions
Supplementary Materials
Author Contributions
Funding
Institutional Review Board Statement
Informed Consent Statement
Data Availability Statement
Conflicts of Interest
References
- Annamalai, R.T.; Hong, X.W.; Schott, N.G.; Tiruchinapally, G.; Levi, B.; Stegemann, J.P. Injectable osteogenic microtissues containing mesenchymal stromal cells conformally fill and repair critical-size defects. Biomaterials 2019, 208, 32–44. [Google Scholar] [CrossRef] [PubMed]
- Maraldi, T.; Riccio, M.; Pisciotta, A.; Zavatti, M.; Carnevale, G.; Beretti, F.; La Sala, G.B.; Motta, A.; De Pol, A. Human amniotic fluid-derived and dental pulp-derived stem cells seeded into collagen scaffold repair critical-size bone defects promoting vascularization. Stem Cell Res. Therapy 2013, 4, 53. [Google Scholar] [CrossRef] [PubMed]
- Kohane, D.S.; Langer, R. Biocompatibility and drug delivery systems. Chem. Sci. 2010, 1, 441–446. [Google Scholar] [CrossRef]
- McEntire, B.J.; Bal, B.S.; Rahaman, M.N.; Chevalier, J.; Pezzotti, G. Ceramics and ceramic coatings in orthopaedics. J. Eur. Ceram. Soc. 2015, 35, 4327–4369. [Google Scholar] [CrossRef]
- Tian, X.H.; Zhao, J.; Wang, Z.B.; Liu, X.H. Design and fabrication of Si3N4/(W, Ti)C graded nano-composite ceramic tool materials. Ceram. Int. 2016, 42, 13497–13506. [Google Scholar] [CrossRef]
- Amaral, M.; Lopes, M.A.; Silva, R.F.; Santos, J.D. Densification route and mechanical properties of Si3N4-bioglass biocomposites. Biomaterials 2002, 23, 857–862. [Google Scholar] [CrossRef]
- Muthunilavan, N.; Rajaram, G. Effect on lubrication regimes with silicon nitride and bearing steel balls. Tribol. Int. 2017, 116, 403–413. [Google Scholar] [CrossRef]
- Shen, Y.D.; Fang, K.; Xiang, Y.; Xu, K.Y.; Yu, L.; Chen, J.Q.; Ma, P.P.; Cai, K.Y.; Shen, X.K.; Liu, J.S. Improvement in osteogenesis, vascularization, and corrosion resistance of titanium with silicon-nitride doped micro-arc oxidation coatings. Front. Bioeng. Biotechnol. 2022, 10, 1023032. [Google Scholar] [CrossRef]
- Hu, F.; Xie, Z.P.; Zhang, J.; Hu, Z.L.; An, D. Promising high-thermal-conductivity substrate material for high-power electronic device: Silicon nitride ceramics. Rare Met. 2020, 39, 463–478. [Google Scholar] [CrossRef]
- Silva, C.C.G.; Higa, O.Z.; Bressiani, J.C. Cytotoxic evaluation of silicon nitride-based ceramics. Mater. Sci. Eng. C-Biomim. Supramol. Syst. 2004, 24, 643–646. [Google Scholar] [CrossRef]
- Neumann, A.; Reske, T.; Held, M.; Jahnke, K.; Ragoss, C.; Maier, H.R. Comparative investigation of the biocompatibility of various silicon nitride ceramic qualities in vitro. J. Mater. Sci.-Mater. Med. 2004, 15, 1135–1140. [Google Scholar] [CrossRef]
- Cappi, B.; Neuss, S.; Salber, J.; Telle, R.; Knüchel, R.; Fischer, H. Cytocompatibility of high strength non-oxide ceramics. J. Biomed. Mater. Res. Part A 2010, 93A, 67–76. [Google Scholar] [CrossRef] [PubMed]
- Guedes e Silva, C.C.; Konig, B., Jr.; Carbonari, M.J.; Yoshimoto, M.; Allegrini, S., Jr.; Bressiani, J.C. Tissue response around silicon nitride implants in rabbits. J. Biomed. Mater. Res. Part A 2008, 84A, 337–343. [Google Scholar] [CrossRef] [PubMed]
- Howlett, C.R.; McCartney, E.; Ching, W. The effect of silicon nitride ceramic on rabbit skeletal cells and tissue. An in vitro and in vivo investigation. Clin. Orthop. Relat. Res. 1989, 244, 293–304. [Google Scholar] [CrossRef]
- Neumann, A.; Unkel, C.; Werry, C.; Herborn, C.U.; Maier, H.R.; Ragoss, C.; Jahnke, K. Prototype of a silicon nitride ceramic-based miniplate osteofixation system for the midface. Otolaryngol.-Head Neck Surg. 2006, 134, 923–930. [Google Scholar] [CrossRef] [PubMed]
- Dai, Y.; Chu, L.Y.; Luo, Z.L.; Tang, T.T.; Wu, H.; Wang, F.; Mei, S.Q.; Wei, J.; Wang, X.H.; Shang, X.F. Effects of a Coating of Nano Silicon Nitride on Porous Polyetheretherketone on Behaviors of MC3T3-E1 Cells In Vitro and Vascularization and Osteogenesis In Vivo. Acs Biomater. Sci. Eng. 2019, 5, 6425–6435. [Google Scholar] [CrossRef]
- Dai, Y.; Guo, H.; Chu, L.Y.; He, Z.H.; Wang, M.Q.; Zhang, S.H.; Shang, X.F. Promoting osteoblasts responses in vitro and improving osteointegration in vivo through bioactive coating of nanosilicon nitride on polyetheretherketone. J. Orthop. Transl. 2020, 24, 198–208. [Google Scholar] [CrossRef]
- Kersten, R.F.M.R.; Wu, G.; Pouran, B.; van der Veen, A.J.; Weinans, H.H.; de Gast, A.; Öner, F.C.; van Gaalen, S.M. Comparison of polyetheretherketone versus silicon nitride intervertebral spinal spacers in a caprine model. J. Biomed. Mater. Res. Part B Appl. Biomater. 2019, 107, 688–699. [Google Scholar] [CrossRef]
- Pezzotti, G.; Bock, R.M.; Adachi, T.; Rondinella, A.; Boschetto, F.; Zhu, W.; Marin, E.; McEntire, B.; Bal, B.S.; Mazda, O. Silicon nitride surface chemistry: A potent regulator of mesenchymal progenitor cell activity in bone formation. Appl. Mater. Today 2017, 9, 82–95. [Google Scholar] [CrossRef]
- Mobbs, R.J.; Rao, P.J.; Phan, K.; Hardcastle, P.; Choy, W.J.; McCartney, E.R.; Druitt, R.K.; Mouatt, C.A.L.; Sorrell, C.C. Anterior Lumbar Interbody Fusion Using Reaction Bonded Silicon Nitride Implants: Long-Term Case Series of the First Synthetic Anterior Lumbar Interbody Fusion Spacer Implanted in Humans. World Neurosurg. 2018, 120, 256–264. [Google Scholar] [CrossRef]
- Pezzotti, G. Bioceramics are not bioinert. Mater. Today 2017, 20, 395–398. [Google Scholar] [CrossRef]
- Pezzotti, G. Silicon Nitride: A Bioceramic with a Gift. Acs Appl. Mater. Interfaces 2019, 11, 26619–26636. [Google Scholar] [CrossRef] [PubMed]
- Gorth, D.J.; Puckett, S.; Ercan, B.; Webster, T.J.; Rahaman, M.; Bal, B.S. Decreased bacteria activity on Si3N4 surfaces compared with PEEK or titanium. Int. J. Nanomed. 2012, 7, 4829–4840. [Google Scholar] [CrossRef]
- Du, X.Y.; Lee, S.S.; Blugan, G.; Ferguson, S.J. Silicon Nitride as a Biomedical Material: An Overview. Int. J. Mol. Sci. 2022, 23, 6551. [Google Scholar] [CrossRef] [PubMed]
- Wu, H.; Liu, T.; Xu, Z.Y.; Qian, J.; Shen, X.N.; Li, Y.; Pan, Y.K.; Wang, D.Q.; Zheng, K.; Boccaccini, A.R.; et al. Enhanced bacteriostatic activity, osteogenesis and osseointegration of silicon nitride/polyetherketoneketone composites with femtosecond laser induced micro/nano structural surface. Appl. Mater. Today 2020, 18, 100523. [Google Scholar] [CrossRef]
- Pezzotti, G.; Bock, R.M.; McEntire, B.J.; Jones, E.; Boffelli, M.; Zhu, W.; Baggio, G.; Boschetto, F.; Puppulin, L.; Adachi, T.; et al. Silicon Nitride Bioceramics Induce Chemically Driven Lysis in Porphyromonas gingivalis. Langmuir 2016, 32, 3024–3035. [Google Scholar] [CrossRef]
- Wu, J.; Liu, Y.; Zhang, H.; Wu, Y.; Chu, Z.; Wu, Q.; Lu, M.; Tang, C. Silicon nitride as a potential candidate for dental implants: Osteogenic activities and antibacterial properties. J. Mater. Res. 2021, 36, 1866–1882. [Google Scholar] [CrossRef]
- Bock, R.M.; Jones, E.N.; Ray, D.A.; Bal, B.S.; Pezzotti, G.; McEntire, B.J. Bacteriostatic behavior of surface modulated silicon nitride in comparison to polyetheretherketone and titanium. J. Biomed. Mater. Res. Part A 2017, 105, 1521–1534. [Google Scholar] [CrossRef]
- Fu, L.; Rajaseka, K.; Katsaros, I.; Liu, Y.; Wang, H.; Engqvist, H.; Xia, W. Enhanced Bacteriostatic Properties of Ti Alloys by Surface Nitriding. Biomed. Mater. Devices 2023. [Google Scholar] [CrossRef]
- Boschetto, F.; Toyama, N.; Horiguchi, S.; Bock, R.M.; McEntire, B.J.; Adachi, T.; Marin, E.; Zhu, W.L.; Mazda, O.; Bal, B.S.; et al. In vitro antibacterial activity of oxide and non-oxide bioceramics for arthroplastic devices: II. Fourier transform infrared spectroscopy. Analyst 2018, 143, 2128–2140. [Google Scholar] [CrossRef]
- Boschetto, F.; Adachi, T.; Horiguchi, S.; Marina, E.; Paccotti, N.; Asai, T.; Zhu, W.L.; McEntire, B.J.; Yamamoto, T.; Kanamura, N.; et al. In situ molecular vibration insights into the antibacterial behavior of silicon nitride bioceramic versus gram-negative Escherichia coli. Spectrochim. Acta Part A—Mol. Biomol. Spectrosc. 2019, 223, 117299. [Google Scholar] [CrossRef] [PubMed]
- Boschetto, F.; Adachi, T.; Horiguchi, S.; Fainozzi, D.; Parmigiani, F.; Marin, E.; Zhu, W.L.; McEntire, B.J.; Yamamoto, T.; Kanamura, N.; et al. Monitoring metabolic reactions in Staphylococcus epidermidis exposed to silicon nitride using in situ time-lapse Raman spectroscopy. J. Biomed. Opt. 2018, 23, 056002. [Google Scholar] [CrossRef]
- Ishikawa, M.; Bentley, K.L.d.M.; McEntire, B.J.; Bal, B.S.; Schwarz, E.M.; Xie, C. Surface topography of silicon nitride affects antimicrobial and osseointegrative properties of tibial implants in a murine model. J. Biomed. Mater. Res. Part A 2017, 105, 3413–3421. [Google Scholar] [CrossRef] [PubMed]
- Oghbaei, M.; Mirzaee, O. Microwave Versus Conventional Sintering: A Review of Fundamentals, Advantages and Applications. J. Alloys Compd. 2010, 494, 175–189. [Google Scholar] [CrossRef]
- Chockalingam, S.; Earl, D.A. Microwave sintering of Si3N4 with LiYO2 and ZrO2 as sintering additives. Mater. Des. 2010, 31, 1559–1562. [Google Scholar] [CrossRef]
- GB/T 16886.12-2005; Biological Evaluation of Medical Devices, Part 12: Sample Preparation And Reference Material. General Administration of Quality Supervision, Inspection and Quarantine of the People’s Republic of China, Standardization Administration of the People’s Republic of China: Beijing, China, 2005.
- ISO 10993-8:2000; Biological Evaluation of Medical Devices—Part 8: Selection and Qualification of Reference Materials for Biological Tests. International Organization for Standardization: Geneva, Switzerland, 2000.
- Bal, B.S.; Rahaman, M.N. Orthopedic applications of silicon nitride ceramics. Acta Biomater. 2012, 8, 2889–2898. [Google Scholar] [CrossRef]
- Kawai, C.; Yamakawa, A. Effect of Porosity and Microstructure on the Strength of Si3N4: Designed Microstructure for High Strength, High Thermal Shock Resistance, and Facile Machining. J. Am. Ceram. Soc. 1997, 80, 2705–2708. [Google Scholar] [CrossRef]
- Wu, J.Q.; Yuan, F.L.; Zeng, X.J.; Rao, P.G. Effect of cation extraction on the oxidation resistance of Si3N4. In High-Performance Ceramics Iii, Pts 1 and 2; Pan, W., Gong, J.H., Ge, C.C., Li, J.F., Eds.; Key Engineering Materials; Trans Tech Publications Ltd.: Shenzhen, China, 2005; Volume 280–283, pp. 1263–1266. [Google Scholar]
- López-López, I.I.; Contreras, A.; Morales-Estrella, R.; Lemus-Ruiz, J. Kinetics Evaluation of Passive Oxidation at High Temperature of Silicon Nitride Used in the Fabrication of Lightweight Metal Matrix Composites. Silicon 2023, 15, 3181–3192. [Google Scholar] [CrossRef]
- Deschaux-Beaume, F.; Cutard, T.; Fréty, N.; Levaillant, C. Oxidation of a silicon nitride-titanium nitride composite: Microstructural investigations and phenomenological modeling. J. Am. Ceram. Soc. 2002, 85, 1860–1866. [Google Scholar] [CrossRef]
- Yang, J.F.; Zhang, G.J.; Ohji, T. Porosity and microstructure control of porous ceramics by partial hot pressing. J. Mater. Res. 2001, 16, 1916–1918. [Google Scholar] [CrossRef]
- Hampshire, S.; Pomeroy, M.J. Oxynitride glasses. Int. J. Appl. Ceram. Technol. 2008, 5, 155–163. [Google Scholar] [CrossRef]
- Hampshire, S. Oxynitride glasses, their properties and crystallisation—A review. J. Non-Cryst. Solids 2003, 316, 64–73. [Google Scholar] [CrossRef]
- Yang, J.F.; Ohji, T.; Niihara, K. Influence of yttria-alumina content on sintering behavior and microstructure of silicon nitride ceramics. J. Am. Ceram. Soc. 2000, 83, 2094–2096. [Google Scholar] [CrossRef]
- Fox, K.M.; Hellmann, J.R. Microstructure and creep behavior of silicon nitride and SiAlONs. Int. J. Appl. Ceram. Technol. 2008, 5, 138–154. [Google Scholar] [CrossRef]
- Kim, E.J.; Bu, S.Y.; Sung, M.K.; Choi, M.K. Effects of Silicon on Osteoblast Activity and Bone Mineralization of MC3T3-E1 Cells. Biol. Trace Elem. Res. 2013, 152, 105–112. [Google Scholar] [CrossRef]
- Kue, R.; Sohrabi, A.; Nagle, D.; Frondoza, C.; Hungerford, D. Enhanced proliferation and osteocalcin production by human osteoblast-like MG63 cells on silicon nitride ceramic discs. Biomaterials 1999, 20, 1195–1201. [Google Scholar] [CrossRef]
- Awad, K.R.; Ahuja, N.; Shah, A.; Tran, H.; Aswath, P.B.; Brotto, M.; Varanasi, V. Silicon nitride enhances osteoprogenitor cell growth and differentiation via increased surface energy and formation of amide and nanocrystalline HA for craniofacial reconstruction. Med. Devices Sens. 2019, 2, e10032. [Google Scholar] [CrossRef]
- Gyorgyey, A.; Ungvari, K.; Kecskemeti, G.; Kopniczky, J.; Hopp, B.; Oszko, A.; Pelsoczi, I.; Rakonczay, Z.; Nagy, K.; Turzo, K. Attachment and proliferation of human osteoblast-like cells (MG-63) on laser-ablated titanium implant material. Mater. Sci. Eng. C—Mater. Biol. Appl. 2013, 33, 4251–4259. [Google Scholar] [CrossRef]
- Davidenko, N.; Schuster, C.F.; Bax, D.V.; Farndale, R.W.; Hamaia, S.; Best, S.M.; Cameron, R.E. Evaluation of cell binding to collagen and gelatin: A study of the effect of 2D and 3D architecture and surface chemistry. J. Mater. Sci.—Mater. Med. 2016, 27, 148. [Google Scholar] [CrossRef]
- Desrousseaux, C.; Sautou, V.; Descamps, S.; Traore, O. Modification of the surfaces of medical devices to prevent microbial adhesion and biofilm formation. J. Hosp. Infect. 2013, 85, 87–93. [Google Scholar] [CrossRef]
- Bock, R.M.; McEntire, B.J.; Bal, B.S.; Rahaman, M.N.; Boffelli, M.; Pezzotti, G. Surface modulation of silicon nitride ceramics for orthopaedic applications. Acta Biomater. 2015, 26, 318–330. [Google Scholar] [CrossRef] [PubMed]

| Materials | Density (g/cm3) | Vickers Hardness (GPa) | Flexural Strength (MPa) | Compressive Strength (MPa) | Fracture Toughness (MPa·m1/2) |
|---|---|---|---|---|---|
| MS Si3N4 | 3.198 ± 0.030 | 14.83 ± 0.33 | 621 ± 63 | 2586 ± 265 | 8.12 ± 0.54 |
| GPS Si3N4 | 3.207 ± 0.021 | 14.73 ± 0.28 | 523 ± 55 | 2465 ± 210 | 7.47 ± 0.41 |
| Titanium alloy [38] | 4.43 | 3.4 | / | 950–990 | 75 |
| Alumina ceramic [38] | 3.986 | 14–16 | 300–500 | 2000–3000 | 4–5 |
| PEEK [38] | 1.29 | / | 160–180 | 130–140 | / |
Disclaimer/Publisher’s Note: The statements, opinions and data contained in all publications are solely those of the individual author(s) and contributor(s) and not of MDPI and/or the editor(s). MDPI and/or the editor(s) disclaim responsibility for any injury to people or property resulting from any ideas, methods, instructions or products referred to in the content. |
© 2023 by the authors. Licensee MDPI, Basel, Switzerland. This article is an open access article distributed under the terms and conditions of the Creative Commons Attribution (CC BY) license (https://creativecommons.org/licenses/by/4.0/).
Share and Cite
He, J.; Liu, Y.; Zeng, X.; Tong, Y.; Liu, R.; Wang, K.; Shangguan, X.; Qiu, G.; Sipaut, C.S. Silicon Nitride Bioceramics Sintered by Microwave Exhibit Excellent Mechanical Properties, Cytocompatibility In Vitro, and Anti-Bacterial Properties. J. Funct. Biomater. 2023, 14, 552. https://doi.org/10.3390/jfb14110552
He J, Liu Y, Zeng X, Tong Y, Liu R, Wang K, Shangguan X, Qiu G, Sipaut CS. Silicon Nitride Bioceramics Sintered by Microwave Exhibit Excellent Mechanical Properties, Cytocompatibility In Vitro, and Anti-Bacterial Properties. Journal of Functional Biomaterials. 2023; 14(11):552. https://doi.org/10.3390/jfb14110552
Chicago/Turabian StyleHe, Jiayu, Yuandong Liu, Xiaofeng Zeng, Yan Tong, Run Liu, Kan Wang, Xiangdong Shangguan, Guanzhou Qiu, and Coswald Stephen Sipaut. 2023. "Silicon Nitride Bioceramics Sintered by Microwave Exhibit Excellent Mechanical Properties, Cytocompatibility In Vitro, and Anti-Bacterial Properties" Journal of Functional Biomaterials 14, no. 11: 552. https://doi.org/10.3390/jfb14110552




